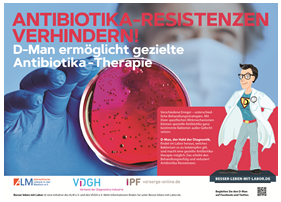
ALM 4. Welle Plakatmotiv Therapie

Vor dem Weltantibiotikatag starten ALM und VDGH ihre 4. Kampagnenwelle
Der D-Man kämpft diesmal gegen Antibiotika-Resistenzen
Berlin, 15. November 2018: Passend zum Weltantibiotikatag am kommenden Sonntag, 18. November, haben die Akkreditierten Labore in der Medizin - ALM e.V. und der Verband der Diagnostica- Industrie e.V.(VDGH) die vierte Welle ihrer gemeinsamem Kampagne „Besser leben mit Labor“ ausgerollt: Mit Plakaten in U- und an S-Bahnstationen sowie in der digitalen Ausgabe der Ärzte Zeitung werben die beiden Verbände für einen verantwortungsbewussten Umgang mit Antibiotika.
Die vierte Mission des eigens für die Kampagne geschaffenen „D-Man“ führt diesen also mitten in eine der dringendsten Aufgaben moderner Diagnostik: die heilsame Wirkung von Antibiotika zu erhalten! „Die Diagnostika-Industrie trägt mit ihren Schlüsseltechnologien dazu bei, dass eine der wirksamsten Waffen der modernen Medizin – die Antibiotika – auch weiter ihre Wirkung entfalten kann“, sagt Ulrich Schmid, stellvertretender Vorstandsvorsitzender des VDGH. „Mit Hilfe von ärztlicher Labordiagnostik lassen sich Viren von Bakterien unterscheiden, Bakterienstämme genau identifizieren und ebenso feststellen, welches am besten wirkende Antibiotikum verordnet werden kann“, betont auch Dr. Michael Müller, 1. Vorsitzender des ALM e.V. Durch einen sorgsamen Umgang der Ärzte in Klinik und Praxis beim Einsatz von Antibiotika, der auch mit richtig eingesetzter Labordiagnostik unterstützt werden kann, ließe sich so die Ausbreitung multiresistenter Keime besser kontrollieren.
„Gemeinsam wollen wir einen Beitrag dazu leisten, dass die Ausbreitung von Antibiotikaresistenzen gestoppt wird“, betonen ALM und VDGH. Hierzu seien Aufklärungskampagnen wie die der beiden Verbände dringend notwendig: Einer Forsa-Umfrage im Auftrag der DAK-Gesundheit aus dem Jahre 2017 zufolge erwarten 72 Prozent der Patienten, dass ihnen ihr Arzt bei einer Erkältung ein Antibiotikum verschreibt. Dabei wirken Antibiotika ausschließlich gegen Bakterien. Jede Grippe und nahezu alle Erkältungen werden jedoch von Viren ausgelöst. „Gegen Erkältungs- und andere Viren sind Antibiotika machtlos. Wenn bei viralen Infektionen also Antibiotika eingenommen werden, dann hilft es nicht - sondern schadet. Denn die unnötige Einnahme von Antibiotika verschärft die Entwicklung von Resistenzen“, warnen ALM und VDGH deshalb auf Plakaten, Postkarten und im Internet.
Mehr zur Kampagne und zu den Themenfeldern der Labormedizin und der Diagnostik finden Sie unter www.besser-leben-mit-labor.de